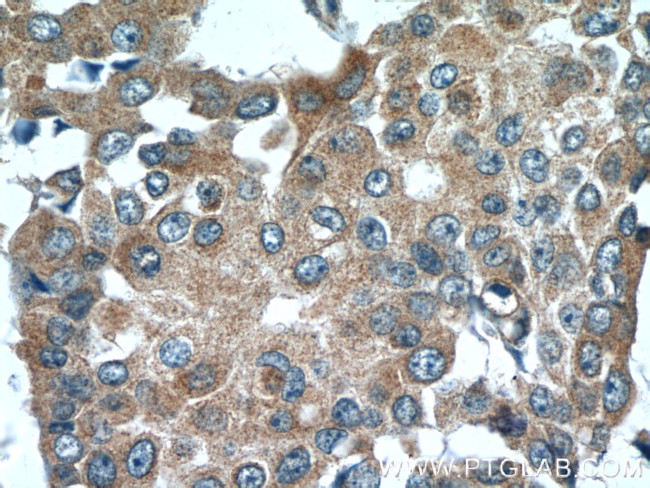
FGFBP1 Antibody in Immunohistochemistry (Paraffin) (IHC (P))
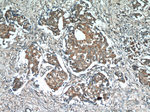
FGFBP1 Antibody in Immunohistochemistry (Paraffin) (IHC (P))
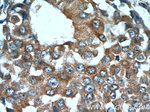
FGFBP1 Antibody in Immunohistochemistry (Paraffin) (IHC (P))
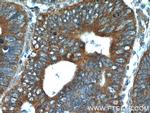
FGFBP1 Antibody in Immunohistochemistry (Paraffin) (IHC (P))

Search
Proteintech
FGFBP1 Polyclonal Antibody
{{$productOrderCtrl.translations['antibody.pdp.commerceCard.promotion.promotions']}}
{{$productOrderCtrl.translations['antibody.pdp.commerceCard.promotion.viewpromo']}}
{{$productOrderCtrl.translations['antibody.pdp.commerceCard.promotion.promocode']}}: {{promo.promoCode}} {{promo.promoTitle}} {{promo.promoDescription}}. {{$productOrderCtrl.translations['antibody.pdp.commerceCard.promotion.learnmore']}}
产品信息
25006-1-AP
种属反应
宿主/亚型
分类
类型
抗原
偶联物
形式
浓度
规格
纯化类型
保存液
内含物
保存条件
运输条件
产品详细信息
Immunogen sequence: MKICSLTLL SFLLLAAQVL LVEGKKKVKN GLHSKVVSEQ KDTLGNTQIK QKSRPGNKGK FVTKDQANCR WAATEQEEGI SLKVECTQLD HEFSCVFAGN PTSCLKLKDE RVYWKQVARN LRSQKDICRY SKTAVKTRVC RKDFPESSLK LVSSTLFGNT KPRKEKTEMS PREHIKGKET TPSSLAVTQT MATKAPECVE DPDMANQRKT ALEFCGETWS SLCTFFLSIV QDTSC (1-234 aa encoded by BC003628)
靶标信息
FGFBP1 encodes a secreted fibroblast growth factor carrier protein. The encoded protein plays a critical role in cell proliferation, differentiation and migration by binding to fibroblast growth factors and potentiating their biological effects on target cells. The encoded protein may also play a role in tumor growth as an angiogenic switch molecule, and expression of this gene has been associated with several types of cancer including pancreatic and colorectal adenocarcinoma. A pseudogene of this gene is also located on the short arm of chromosome 4.
仅用于科研。不用于诊断过程。未经明确授权不得转售。
生物信息学
蛋白别名: 17 kDa HBGF-binding protein; 17 kDa heparin-binding growth factor-binding protein; FGF-binding protein 1; FGF-BP; Fibroblast growth factor-binding protein 1; heparin-binding growth factor binding protein; unnamed protein product
基因别名: FGF-BP; FGF-BP1; FGFBP; FGFBP-1; FGFBP1; HBP17
UniProt ID: (Human) Q14512, (Mouse) O70514
Entrez Gene ID: (Human) 9982, (Mouse) 14181